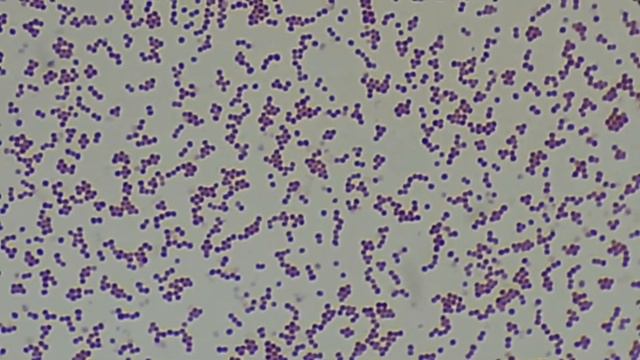
Klebsiella,Staphylococcus,E coli, Candida,Acinetobacter,Bacillus in Gram stain Under the Microscop смотреть онлайн

Автор: Огородные фантазии Страница 3

Новинки в сфере образования представили на форуме «Качество образования – качество жизни»

Что я раскрасила за месяц? Октябрь/Сентябрь 2019

6 листопада українська мова

ВОРКАУТ ЗАРУБА ШКОЛЬНИКОВ КРАСНЫЕ ПРОТИВ СИНИХ!!! ЭТО ЖЕСТЬ! 😱😱😱

Πλεκτη Καζακα (μερος 2ο)

Pokémon VGC Platinum REDUX Gardenia Rematch

Садовые цветы дома #877
Klebsiella,Staphylococcus,E coli, Candida,Acinetobacter,Bacillus in Gram stain Under the Microscop

mere Abbu ka Naam hai Tera per meri ammi ka naam hai#shorta #comedy #video #viral 🤣🤣🤓😂😂👍
![[#29]Checking my plants/Sunburn😢 #Succulent by MokaMoka смотреть онлайн](https://pic.rutubelist.ru/video/1e/38/1e38f38795a0b396084b3e4c4da07cf9.jpg?size=m)
[#29]Checking my plants/Sunburn😢 #Succulent by MokaMoka

Сергей Жидков

Игорь Николаев. Дельфин и русалка. 26.03.2023. КЗ Арбат.

Новый год с Фиксиками

"The Wild Life" Slaughter@Merriweather Post Pavilion Columbia, MD 4/30/16 M3 Festival

나무가 되어버린 #제라늄 라라딜라이트 라라하모니 장정합니다 #헤라의정원

2000 subscriber giveaway + New Plants, and an easy Diy Terracotta Pot Project

эустома и пеларгонии в январе.

Я и Мир "НАРЦИСС"

ДРОПНУЛ ЭЛО ЧТОБЫ ПРОКНУТЬ С ГЕНОЙ

7DS: Grand Cross - Небольшая информация по обновлению 25.08.20 !

Echeveria Pastel Leon

В Брянской области определились победитель и призеры юношеского турнира «Золотая шайба»

|НАШИТЕ ЦВЕТЯ| Мини карамфил - цвят цикламен

Soldes Hiver 2019 (Sephora, Bourjois, Lush)
За каждым успешным каналом стоит личность, идея и сотни часов кропотливого труда. Если вы здесь, значит, автор «Огородные фантазии» уже сумел зацепить ваше внимание своим уникальным стилем или подачей. А мы на RUVIDEO позаботились о том, чтобы вы могли изучить весь архив его работ в максимально комфортных условиях — без лишней суеты и преград.
Почему за работами канала «Огородные фантазии» так интересно наблюдать? Всё просто: это честный контент, который находит отклик в сердцах зрителей. На нашем ресурсе вы можете смотреть онлайн все видео любимого автора бесплатно и в хорошем качестве. Нам важно, чтобы вы видели каждую деталь и слышали каждый нюанс, поэтому мы используем только стабильные плееры из открытых источников Rutube.
Следите за новинками канала, пересматривайте старые шедевры и открывайте для себя новые грани творчества «Огородные фантазии». Мы постоянно обновляем ленту, чтобы у вас под рукой всегда были самые свежие выпуски. Никаких сложных регистраций — только вы и творчество, которое вдохновляет. Приятного вам путешествия по миру авторского контента на RUVIDEO!
Видео взято из открытых источников Rutube. Если вы правообладатель, обратитесь к первоисточнику.